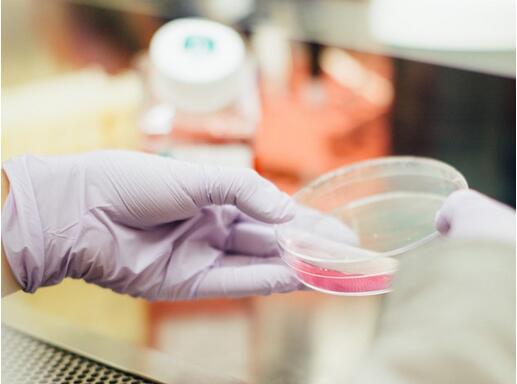
如何鉴别葡萄酒的真伪方法,如何一眼就辨别葡萄酒的真假

网上流传的诸多鉴别葡萄酒真假、品质的办法,真的靠谱吗?

检测方法一:碱+白醋检测法
操作方法:先把碱面放入红酒中搅拌,真葡萄酒会变黑或者变成蓝黑色;然后加入白醋,搅拌均匀之后,遇碱面变成蓝黑色的葡萄酒立刻又还原到了最初的紫红色(白醋应多于之前放入的碱面量)。
原理:葡萄皮当中含的花色苷遇碱原本的紫色会变成紫黑色、蓝黑色。而加白醋后,与碱反应后的花色苷跟酸再次发生化学反应,变回了原来的紫色,进一步证实了葡萄酒确实是100%葡萄汁的真酒。
推荐指数4颗星:此方法可用于检测干红或者半干红葡萄洒。白葡萄酒、甜葡萄酒、桃红葡萄酒不适用此方法。
检测方法二:卫生纸检测法
操作方法:将葡萄酒滴在纸巾上,红色扩散均匀,没有明显的水迹扩散是真葡萄酒;水迹不断往外扩散,红色区域跟水迹之间分界明显是假葡萄酒。
原理:天然红色素,颗粒非常小,假葡萄酒由于是用苋菜红等化工合成色素勾兑而成的,色素颗粒大会沉淀在餐巾纸的中间,而水迹不断往外扩散。
推荐指数3颗星:此方法对卫生纸的质量要求较高,纸巾质地对液体的扩散有一定的影响。

检测方法三:苏打水检测法
操作方法:红酒滴在折了几层的纸巾上,再滴加苏打水,变成蓝绿色,颜色越深,色素越少。完全没反应的就是纯色素。
原理:同碱+白醋检测法。
推荐指数4颗星:苏打水比较常见,检测方便。

检测方法四:看各种证书
操作方法:有权要求经销商出示该批次葡萄酒的原产地证书、产品报关单和入境货物检疫证明,确认货证相符。
原理:国家质检总局自2010年1月1日起启用新版检验检疫证书,新版证书增加了底纹防复印的特点,证单底纹为天蓝色,含有隐含特征,正常情况下观察,隐含特征不可见,但复印件上会出现清晰的“COPY”字样。
推荐指数5颗星:对所有葡萄酒都适用。

检测方法五:看酒标和条形码
操作方法:看酒瓶背标印刷是否清晰,是否仿冒翻印,背标的内容是否和正标的外文内容完全相同,条码69开头的都是中国生产。
原理:所以在中国出售的进口葡萄酒都必须要有符合规定的中文背标。
推荐指数4颗星:对于不懂酒的人来说看酒标有难度。

这些方法都只能鉴别葡萄酒是否是真的,或者是进口的。想喝优质葡萄酒,最有效的方法还是找正规的渠道购买。另外,增加自己的葡萄酒知识也很重要,要不然,就算给你喝,你也不一定能分辨是真还是假。